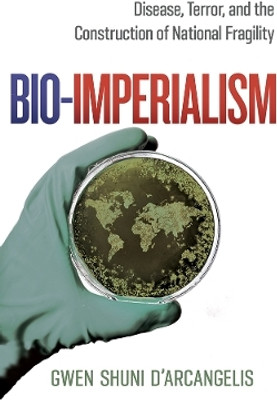
Bio-Imperialism(English, Electronic book text, D'Arcangelis Gwen Shuni)

Bio-Imperialism(English, Electronic book text, D'Arcangelis Gwen Shuni)
Quick Overview
Product Price Comparison
Bio-Imperialism focuses on an understudied dimension of the war on terror: the fight against bioterrorism. This component of the war enlisted the biosciences and public health fields to build up the U.S. biodefense industry and U.S. global disease control. The book argues that U.S. imperial ambitions drove these shifts in focus, aided by gendered and racialized discourses on terrorism, disease, and science. These narratives helped rationalize American research expansion into dangerous germs and bioweapons in the name of biodefense and bolstered the U.S. rationale for increased interference in the disease control decisions of Global South nations. Bio-Imperialism is a sobering look at how the war on terror impacted the world in ways that we are only just starting to grapple with.